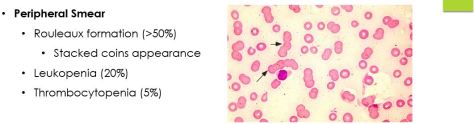
MM6

Who gets it? Cancer patients who are receiving cytotoxic medications that attack rapidly producing cells. The cells most affected are those in the bone marrow leading to immunosuppression and those in the GI tract leading to increased risk for translocation of gut bacteria into the bloodstream. Keep in mind that these patients may not show the normal inflammatory response and therefore, fever may be their only sign of infection!
What is neutropenia? ANC < 1500. Severe neutropenia is ANC < 500 or ANC expected to drop < 500 within 48 hours.
What is neutropenic fever? According to the IDSA 2010 guidelines, neutropenic fever is a fever in a neutropenic patient of 38.3 once or 38 sustained over an hour.
How do you measure a fever? The best way to measure is oral (as compared to tympanic, axillary, or rectal) but the only time an oral temperature may be less accurate is if the patient has mucositis or oral ulcers.
What antibiotics should you start these patients on? The goal is to cover GPCs from the mouth and GNRs from the GI tract. The best 3 antibiotics are cefepime, meropenem, or zosyn. Add vanc if: evidence of mucositis, severe sepsis or patient unstable, pneumonia, patient with MRSA colonization, the patient has a central line, if the patient has been on prophylactic antibiotics previously, or if the patient has a soft tissue or skin infection. Add antifungals if: the patient has a persistent fever despite broad spectrum antibiotics or if the patient is hemodynamically unstable.
Low risk patients (those without comorbid conditions) should not be put on prophylactic antibiotics.




















Labs will show:
Treatment
Consequences of ATRA
Platelet transfusion goals